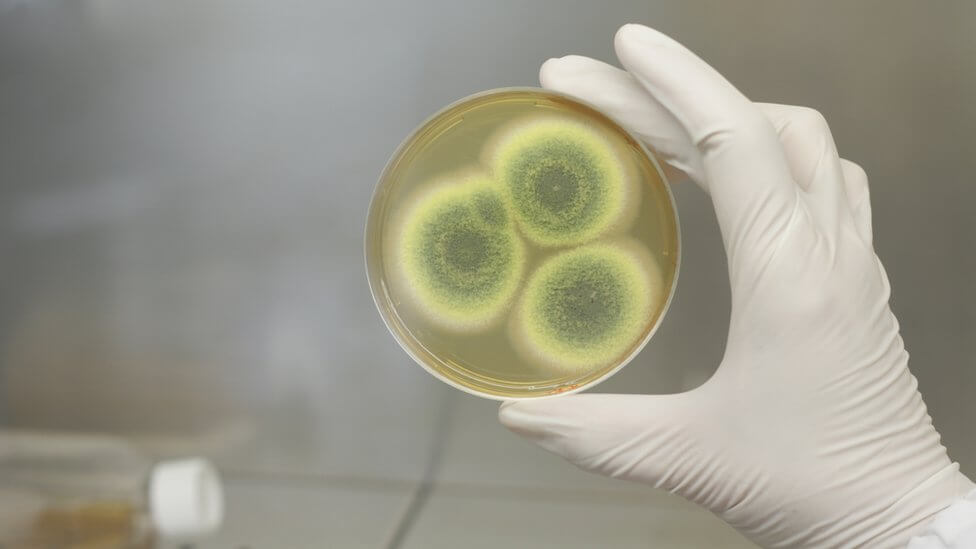
Пенициллин впервые стали применять в медицине в 40-х годах XX века. Фото.

Создание антибиотиков стало одним из самых серьезных прорывов человечества в области медицины. Благодаря этим препаратам многие неизлечимые болезни стали не более опасными, чем сезонная простуда. Единственный серьезный недостаток антибиотиков — бактерии и вирусы к ним со временем адаптируются. В результате для эффективной борьбы с ними необходимы все более мощные антибиотики. Другими словами, использование антибиотиков — один из факторов появления устойчивых к ним бактерий, так называемых супербактерий. Однако, как показало недавнее исследование, супербактерии существовали задолго до того, как люди начали применять антибиотики. В частности, ученые выяснили, что к возникновению одного из видов супербактерий привела эволюционная битва между грибками и бактериями на коже ежей.

Ежи породили супербактерий за долго до появления антибиотиков
Как бактерии научились противостоять антибиотикам
Группа ученых исследовала бактерии MRSA (метициллин-резистентного золотистого стафилококка), а также грибок, который живет на коже ежей вида Erinaceus europaeus, проживающих на территории Европы. Исследование показало, что грибок и бактерии буквально сражаются между собой за выживание на коже животных. Чтобы уничтожить золотистый стафилококк, грибок выделяет пенициллиновые антибиотики естественным образом. Бактерии же, как я сказал выше, с целью выживания постепенно становятся устойчивыми к антибиотику.

На коже 60% ежей имеются опасные для человека бактерии MRSA
Конечно, применение антибиотиков в медицине тоже стимулирует появление устойчивых к ним бактерий. Однако, как показывает исследование, этот процесс также происходит и в природе без участия человека. Возможно, обнаруженный естественный механизм объясняет, как у бактерий возникли гены резистентности, то есть устойчивости к антибиотикам.
Гены резистентности возникли в геноме патогенов задолго до того, как антибиотики начали применяться в медицине. Использование грибками антибиотиков действительно объясняет, как это могло произойти” — говорит один из авторов работы Юэн Харрисон, сотрудник Кембриджского университета.
Но из всего вышесказанного возникает вопрос — когда впервые появились на ежах устойчивые к пенициллину бактерии? Возможно, это произошло уже после того, как в медицине стали широко применяться антибиотики. Чтобы выяснить это, авторы работы секвенировали геном бактерий и определили дату появления гена устойчивости к антибиотику.
Чтобы вычислить дату, авторы работы измеряли количество определенных мутаций в геноме, которые всегда возникают через определенный промежуток времени. Такие мутации можно сравнить с годовыми кольцами, по которым можно установить возраст срубленного дерева. Исследование показало, что бактерии научились противостоять пенициллину еще в XIX веке. Напомню, что антибиотик стали применять только в 40-х годах прошлого века.
Пенициллин впервые стали применять в медицине в 40-х годах XX века
Кроме того, ученые в своей работе секвинировали геномы грибков, живущих на коже ежей, и смогли установить гены, отвечающие за выработку пенициллиновых антибиотиков. Подробности исследования опубликованы в журнале Nature.
Ежи заразили людей супербактериями?
MRSA представляет собой один из штаммов стафилококковых бактерий. Как и некоторые другие стафилококки, он обладает резистентностью к антибиотикам. Эти бактерии опасны для человека, причем, из-за устойчивости к антибиотикам, они очень тяжело поддаются лечению. Правда, в последнее время ученые уже разработали технологию борьбы с золотистым стафилококком, но препаратов на ее основе еще не существует.
Согласно данным, озвученным Кембриджским университетом, mecC-MRSA, обнаруженный на ежах, представляет собой достаточно редкий вариант супербактерии. На него приходится один из двух сотен случаев заражения человека MRSA.
Подписывайтесь на наш Пульс Mail.ru, где вы найдете еще больше интересных материалов.
MecC-MRSA впервые был обнаружен в 2011 году. Изначально ученые предполагали, что этот штамм возник у коров, которые получали большое количество антибиотиков. Однако исследование показало, что 60% европейских ежей являются его носителями. Поэтому авторы работы предполагают, что этот тип вируса впервые появился именно у ежей, а не у коров. Однако как бактерии перешли людям, пока неизвестно. Вполне возможно, что это случилось в результате прямого контакта с ежами.
Кроме того, как я сказал выше, MecC-MRSA был обнаружен у домашнего скота. Другими словами, он также мог перейти человеку через любого животного-посредника. Напоследок напомню, что появлению устойчивых к антибиотикам бактерий также способствует микропластик в воде, о чем я рассказывал ранее.



Новости, статьи и анонсы публикаций
Чат с читателямиСвободное общение и обсуждение материалов